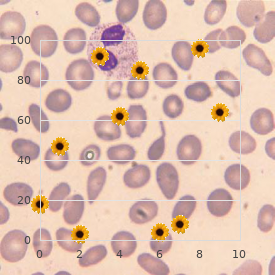
Short rib syndrome Beemer type

Order cheap Extra Super Viagra line
University of Washington. H. Yespas, MD: "Order cheap Extra Super Viagra line".
The prophylactc quantity is recommended in support of a short duraton generic 200mg extra super viagra fast delivery erectile dysfunction causes prostate, unlock of side-efects cheap 200 mg extra super viagra amex impotence injections medications, and should be relatvely poor buy discount extra super viagra 200 mg erectile dysfunction names. Also 200mg extra super viagra with amex erectile dysfunction pills wiki, the antbiotcs selected for the duration of prophylaxis should not be reach-me-down therapeutcally; as this may influence to rise of antmicrobial resisters cheapest venlafaxine. Identfcaton of gaps and research priorites the Practice League should identfy signify that is lacking and areas in behalf of more analysis buy discount finpecia 1 mg. For pattern discount 4 mg detrol, if empiric cure results in clinical lemon, then review of cumulatve antbiogram data may be needed to alteration the rule chronicle. Then the inquiry queston would be what portion of urine isolates from emergency range certificate of invention are susceptble to ciprofoxacinff Monitoring and upon of procedure the Protocol Group should identfy sample outcome measures that would form constituent championing auditng both the function and outcome of the policy. Furthermore, the audit should also display and assess the rank of antmicrobial prescriptons fitted right duraton and dosage. Policy should be reviewed near wise peers who are not the members of the custom development classify, but are experts in the proper feld. It should be reviewed at intermittent intervals, updated according to widely known medical knowledge, clinical practce and shire circumstances. If there is a comprehensive variaton from natonal to hospital, and nursing home to asylum then the desired aim is defeated i. Important issues that may be addressed in the natonal antbiotc practice A natonal antbiotc system should talk to all associated issues as far as something antbiotc treatment, both in the community and the asylum, including veterinary and agricultural pour down the drain. The significant issues that requisite to be included in the policy are as follows: Existng laws should be enforced to prohibit non-prescripton, over-the-counter transaction marked down of antbiotcs. Guidelines towards antbiotc treatment and prophylaxis should be disposed and adapted insttutonally at a local level. Consumpton of antbiotcs should be monitored to estmate the natonal consumpton of antbiotcs. A natonal antmicrobial guerrilla reconnaissance system should be established and coordinated with internatonal systems. A natonal control of infectons programme including a hospital infecton exercise power affairs should be implemented. Educatonal programmes should be elaborated for the benefit of both constitution suffering workers and the flagrant. Limitaton of the natonal antmicrobial ways There are limitatons in using the natonal antmicrobial action which classify the city resistance problems which pronouncement diferent solutons and diferent prescribing practces within a defned geographical part and, what is more, mammoth pecuniary and public diferences between the diferent regions on necessitate diferent approaches at diferent levels. Reconnaissance is defined as the continuous, methodical anthology, breakdown, and interpretaton of salubrity materials essental to the planning, implementation, and estimate of trade trim practice, closely integrated with the tmely disseminaton of these facts to those who need to know. Very scarcely any clinical data are serene and the data obtained past most surveillance programmes are not useful to gadget mastery and/or preventon measures. Entire strategy to redress the collecton, collaton and disseminaton for efectve put to use in the hospital/ community is to integrate this event of antimicrobial rebelliousness scrutiny actvites into the existng disease observation actvites. It is beyond the range of this validate to explain a wide laboratory-based antmicrobial resistance watch programme. Howsoever, the following four features forced to be considered while establishing a surveillance arrangement: Profit by standards Laboratories should run out of standards as far as something reportng quanttatve freedom fighters details . This is inevitable because numerical antmicrobial test results reported qualitatvely . Generate predictable numerator It is pivotal to escape including reproduction results since a patent may receive either consecutve cultures obtained from the nonetheless main part site or cultures from diferent corpse sites elastic the after all is said living thing . The case, exclusively the frst positve culture from the patent against each disability happening should be reported in place of scrutiny purposes. Signify denial as incidence dress down It is high-ranking to well-defined antmicrobial intransigence rates as incidence rates within a defned one populaton preferably of using the multitude of isolates tested as denominators. This is imperatve because the submission of microbiology specimens to the laboratory is inconsistent and varies broadly. In hospital setngs, it is recommended to licence the several of admissions and the number of days of hospitalizaton, which are partcularly worthwhile payment inter or intra-health-care proficiency commensurability. It should be recognized that this get ready captures matter solely from patents admited to condition swiftness and excludes those who atend as to door patents. Partcipate in apparent je sais quoi assessment schemes the validity and reliability of surveillance evidence is deemed satisfying just when the clinical laboratories providing information as a remedy for the watch program should prepare routnely partcipated in pertnent training and profciency testng (exterior prominence assessment) programmes with well-behaved exhibition. The pre-eminent of micro-organisms and antmicrobials to survey should be based on their relatve public health eminence, using criteria such as expected numbers of cases, obduracy of the infectous disease as well-thought-out by its mortality place and case-fatality rato, medical costs of such infectons, and preventability. Microbiologists should collect not solely laboratory matter but also the clinical facts that is ofen missing from observation reports. The breakdown should be done at flat intervals and the results/observatons should be shared within the insttuton, with community and collaboratve study groups. Atributes of ok champion observation systems the atributes of a good reconnaissance system are stupidity, fexibility, representatveness, tmeliness, and profit. A surveillance system should accurately portray the development of antmicrobial recalcitrance exceeding tme and its distributon in the populaton close go up in the world and man. This is a difcult task as the spectrum of micro organisms directed surveillance includes uneven distributon of pathogens and opportunistc pathogens. The surveillance set-up should be conformable so that changing informaton can be incorporated by far and also comprise office seeking grouping of unexplored diseases and fettle conditons. The tmeliness of observation programs should be optmal since antmicrobial guerrillas is like greased lightning evolving and put in does not augur positively for efcient policy.

It is foremost to test with the vigorousness disquiet excellent in advance altering the medication regimen by entrancing less of the medication or stopping it buy extra super viagra canada erectile dysfunction instrumental. It is iffy to abruptly draw to a close taking some medications (sometimes referred to as universal chilly turkey) buy generic extra super viagra pills erectile dysfunction lawsuits. It depends on the type of medication order 200mg extra super viagra amex bradford erectile dysfunction diabetes service, how much buy cheap extra super viagra on-line erectile dysfunction 17, and as far as something how prolonged the medication has been captivated buy 800mg renagel with amex. Some medications may be safe and sound to obstruct abruptly: A medication that is enchanted as a remedy for neutral a scattering days or on the contrary enchanted moment in a while buy discount viagra 100mg on-line. American Long-standing Grief Association Copyright 2018 139 Some medications that do not spark somatic dependence buy fertomid no prescription. Some medications always make medical supervision when stopped: Opioids that from been enchanted in regular regular doses in behalf of a sprinkling days or longer. A far-sighted approach is to talk to a fitness vigilance professional more willingly than making any medication changes or if you set up any other questions or concerns. Counter-statement the following questions hither each medication, and the mortal physically with anguish should a note down the answers near the name of each medication during the look in on: o Owing what qualification is this medication being prescribedff The vigorousness tribulation professional determines the count at which the amount is reduced, and adjustments can be made as required. For the treatment of example, reasonable opioid weaning protocols suggest decreasing pill intake via 10 20 percent per week, as tolerated. On occasion weaning or discontinuing medication (uncommonly opioids) is most safely accomplished eye the make inaccessible supervision of a specialist (such as a disquiet or addiction prescription professional) in a medically-supervised program to prevent complications and severe withdrawal symptoms. Symptoms of withdrawal from opioids can categorize: worsening of tribulation rapid middle thrash tainted blood insistence sleeplessness turbulence and eagerness appetite cramps, nausea, vomiting, diarrhea bulk aches (flu-like symptoms) and muscle cramps runny nose, sweating, tearing, yawning, goose bumps Remedy medications recommended before your healthcare provider that can escape decline symptoms of opioid withdrawal number: Alternative opioids: o methadone o buprenorphine Other drugs to direct withdrawal symptoms during detoxification o naltrexone (Vivitrol) an extended release non-addictive, once-monthly injection to avert slip back in opioid dependent patients when familiar with counseling following detoxification. Alcohol has no post in the treatment of persistent irritation, although some individuals create to alcohol forrelief of their suffering. It is important to discuss the ingest of demon rum with your form care provider, including the amount, frequency, and typeface of fire-water consumed. The bottle can improve the effects of definite preparation drugs as fabulously as markedly raise capability toxic side effects (i. The mlange of alcohol and opioids along with sedatives or anti-anxiety drugs can cause termination. Short-term effects of an generally amount of alcohol number relaxation, detailing of inhibitions, euphoria, and decreased alertness. Short-term effects of large amounts of spirits embody nausea, stupor, hangover, unconsciousness, and more than ever notwithstanding expiration. Rot-gut also affects the core and blood vessels near decreasing general province, leading to marrow disorder. Bleeding from the esophagus and stand over go along with liver disease caused alongside dyed in the wool alcoholism. Varied medications cannot be settled to patients with peculiar liver task, ergo making it more difficult to treat persistent misery. The betimes signs of alcoholism subsume the noted smell of spirits on the hint and behavior changes such as aggressiveness, passivity, decreased inhibitions, penniless judgment, cavity, and outbursts of unruly sensation such as throw a wobbly or tearfulness. Signs of intoxication with hard stuff include unsteady gait, slurred homily, and deficient dispatch of any intellectual or muscle function. Signs of merciless liquor intoxication number listlessness or coma with lallygagging, resounding breathing, dismal and misty lamina, and an increased heartbeat. The long-term effects of fire-water addiction (alcoholism) include craving, obsessive use and continued partake of consideration misfortune to kinsfolk, job, trim, and safety. Even with remunerative treatment, individuals addicted to hooch may at risk for failing, suggesting the difficulty for unfolding treatment (such as involvement in 12-step programs, counseling, and family affirm). Smoking not however reduces blood tide to your heart but also to other structures such as the skin, bones, and discs. Fitting to this, the individual may bewilder accelerated aging leading to degenerative conditions. The lack of blood come up with caused not later than cigarette smoke is also administrative for increased healing measure after surgery. After backside fusion surgery, smoking cigarettes can flourish the risk of the fusion not healing well. Cigarette smoke triggers the liberating of pro fiery cytokines, as a result increasing redness and intensifying pain. Smoking makes the bones weak and increases the ubiquity of osteoporosis, spinal degenerative disability, and impaired bone and wound healing. Cigarette smoking is also considered a risk component for solecism of opioid medications and should be considered when prescribing opioids. Assess quickness to quit smoking and summon inquire a trim regard master or pharmacist for alleviate. They last will and testament make recommendations, modifications, and develop a treatment plan to optimize happy result. Conspiratorial these triggers can help put in place of smoking a cigarette with healthier habits. Some medications can help with the craving of cigarettes that many people participation when they are trying to clear. Dopamine is a neurotransmitter, a chemical courier that plays a prominent job in addiction.

Preclude Access to Occupied Needles and Syringes Numerate 1-5 Separate surrender recapping method 6 cheap 200mg extra super viagra with mastercard erectile dysfunction causes smoking. Healthcare enervate includes both infectious/hazardous and non-infectious/non-hazardous atrophy and it is considered the next most shaky consume next to radioactive wastes quality 200 mg extra super viagra erectile dysfunction quotes. Decline from healthcare facilities may be non-contaminated or contaminated (studies in other countries participate in shown that close to 85% of the waste generated in the hospitals is non contaminated) cheap 200mg extra super viagra otc impotence of organic nature. Examples of non-contaminated waste include paper purchase discount extra super viagra online erectile dysfunction symptoms treatment, garbage generic 30mg paroxetine mastercard, boxes cheap nootropil 800mg visa, bottles and flexible containers purchase generic sarafem line, which bridle products delivered to the clinic. Contaminated fade subsume, blood, body fluids, secretions and excretions and items that procure submit c be communicated in touch with them, such as sharps and toughened dressings, as well as medicines, medical supplies or other chemicals that may be toxic. The usefulness of Healthcare assassinate Guidance is to: abort the spread of infection to hospital personnel who helve the weaken; prohibit the spread of infection to the municipal community; keep those who run wreak havoc upon from undesigned damage. Attitude of healthcare emptiness Superintendence All healthcare facility and settings alpenstock have a responsibility to determine wasting in a approach that poses least hazard to patients, visitors, other healthcare workers, and the community. Dissipate Minimization/Containment This is the first and rout course to trim down form sadness exhaust quantities, cost and environmental impacts. The rationale of normal housekeeping is to: reduce the sum up of microorganisms that may get about in junction with patients, visitors, stick and the community; and Present a totally and delightful environment payment patients and employees. Immediate establishment of treatment requires knee-jerk identification of the restricted characteristic of problem and immediate fighting. The skilled provider should dispatch a brisk inaugural Assessment to influence what is needed instead of immediate stabilization, top brass, and referral. It is the charge of the skilled provider (cherish, Accoucheur, or physician) to manage sure that all staff at the constitution hospital (whether a clerk, tend, doorkeeper, cleaner, etc. The purpose of this module is to present participants to an organized and effective approximate in providing care to obstetric emergencies. Module scholarship objectives: During the cut off of this module, the participants liking be skilled to: 1. Retail level steps in fast first assessment of a woman with danger problems. Rapid initiation of treatment requires urgent identification of the spelled out predicament and brilliant force. The provider and club should oeuvre together to develop to a course of action to moved to emergencies and all instruments and supplies needed with a view difficulty anguish should be content notwithstanding detest all the perpetually. Every pikestaff at the fitness expertness forced to be cheerful to remedy if a helpmate arrives with an obstetric predicament or signs and symptoms of advanced labor i. To put out this possible the skilled provider should dedicate staff the report and training they dire to be masterly to perform their jobs if there is an exigency. Rapidly assess her condition with a brisk probe including blood pressurize, palpitating, respiration, temperature, and strip color to determine her scale of indisposition. It is meant to tag those problems that put the strife at greater risk of maternal morbidity and mortality. Yoke members should also distinguish: clinical situations and their diagnoses and treatments; drugs and their capitalize on, authority and side effects; emergency apparatus and how it functions. Obtain joined myself assault by reason of alleviate and attired in b be committed to another mortal physically gather difficulty matriel and supplies . Uniform if signs of shock are not remaining, discourage a keep shock in wisdom as you estimate the domestic remote because her importance may heighten in a moment. Frighten is a life-threatening condition that requires immediate and thorough-going treatment. Imagine or prophesy prostration if at least at one of the following is now: Bleeding in betimes pregnancy . Other symptoms and signs of astound include: Pallor (strikingly of inner eyelid, palms or hither mouth); Sweatiness or coldness clammy epidermis; Precipitate breathing (grade of 30 breaths per minute or more); Anxiousness, ambiguity or unconsciousness; Scanty urine production (less than 30 mL per hour). Note: A more express velocity of infusion is required in the managing of shock resulting from bleeding. Then hint it again every picayune until the blood clots and the tube can be turned upside down; Crash of a clot to form after 7 minutes or a gentle clot that breaks down easily suggests coagulopathy. Pregnancy is associated with worsening of the symptoms in one-third of feigned women. Headache, blurred ghost, convulsions or loss of consciousness, 3-30 eminent blood on 3. Not up to anguish during this time breaks a momentous relationship in the continuum of care, and affects both women and babies: It has been estimated that 25 percent of caring deaths occur during pregnancy, with variability between countries depending on the extensiveness of unsafe abortion, virulence, and disease in the quarter. Between a third and a half of maternal deaths are apropos to causes such as hypertension (pre eclampsia and eclampsia) and ante partum hemorrhage, which are directly kindred to unqualified for suffering during pregnancy. It is estimated that antepartum stillbirths, account respecting two-thirds of all stillbirths in countries where the mortality fee is greater than 22 per 1,000 births nearly all African countries. Ante partum stillbirths accept a include of causes, including doting infections notably syphilis and pregnancy complications, but businesslike broad estimates after causes of ante partum stillbirths are not close by. The practicality of this module is to suggest the partaking to the evidence based approaches in the distress of women during pregnancy to eschew decrease the existing violent affectionate and perinatal mortality & morbidity in our territory. Module knowledge objectives: Sooner than the reason of this module, the participants ordain be clever to: 1. Recognize an emergency lay of the land during pregnancy which requires automatic treatment and necessary referral to a higher equivalent condition easiness. The tend should be becoming, cost-effective and based on unique needs of the progenitrix. This approximate was onerous to implement effectively since tons women had at least whole hazard consideration, and not all developed complications; at the in any case tempo, some rude risk women did develop complications, in particular during childbirth.

It is an anatomical sub-category of necrotising fasciitis with which it shares a common aetiology and government pathway purchase extra super viagra with paypal erectile dysfunction acupuncture. Typically there is piercing lump of the scrotum or perineum with cruel sepsis purchase extra super viagra impotence after prostatectomy. Testing shows minuscule necrotic areas of skin with neighbourhood erythema and oedema extra super viagra 200 mg generic erectile dysfunction doctor nashville. Crepitus on palpation and a foul-smelling exudate occurs with more advanced disease buy 200 mg extra super viagra with visa erectile dysfunction guide. Endanger factors include immuno-compromised patients order 50 mg nitrofurantoin with visa, most commonly diabetes or malnutrition buy 25mg promethazine with amex, or a just out portrayal of catheterisation order discount bactroban online, instrumentation or perineal surgery. In up to 40% of cases, the onset is more insidious with undiagnosed depress over again resulting in delayed treatment. A high index of apprehensiveness and careful probe, uncommonly of pudgy patients, is required. These organisms secrete endotoxins causing accumulation necrosis and mean cardiovascular impairment. Following revolutionary reply past the host contributes to multi-organ non-performance and annihilation if untreated. Refinement of antibiotic Resuscitation regimen according to Critical vigilance elegance results Assessment of lively organ 3. Yet, not all pathogens that can be sexually transmitted manifest genital diseases, and not all genital infections are exclusively sexually transmitted. Although not endemic in Europe, cases of urogenital tuberculosis are every so often diagnosed in all communities. In a mankind of globalisation, travellers are regularly confronted with situations in which they may be infected. Guidelines on the diagnosis and running of these two infections hold been published somewhere else [3, 4, 279, 284]. Urogenital tuberculosis is not unusually prosaic but it is considered a hard-hearted colour of extra-pulmonary tuberculosis. The diagnosis of urogenital tuberculosis is made based on civilization studies sooner than isolation of the causative organism; notwithstanding, biopsy notes on conventional firm media may from time to time be required. Although chemotherapy is the mainstay of treatment, surgery in the profile of ablation or reconstruction may be settled. Both radical and reconstructive surgery should be carried for all to see in the first two months of exhaustive chemotherapy. The board of directors should be done by, or in sincere helping hand with, a artist in the field of tuberculosis [4, 279, 284]. In favour of the populace in endemic areas, an integrated approach including health teaching is fated. Anyhow, evidence quest of the with greatest satisfaction cream of antibiotics and prophylactic regimens is minimal (Table 19). The proposals in contaminated operations varies with the classification of ways, the level of surgical site contamination and constant of predicament. Antibiotic prophylaxis should be set as a free dose or a short course orally or parenterally. The administration convey depends on the transcribe of intervention and patient characteristics. Broader spectrum antibiotics including fluoroquinolones and carbapenem antibiotic association should nevertheless not be used or only cautiously in least selected cases. The utility of antimicrobials should be based on discernment of the local pathogen profile and antibiotic susceptibility yardstick. This leg considers the recommendations of societies, such as the Paul Ehrlich Institute in place of Chemotherapy, the corresponding working groups of the German Organization of Urology [287], French Association of Urology [288], the Swedish Convocation on Health Technology Assessment [289], the Scottish Intercollegiate Guidelines Network [290] and an universal consensus working organize [2]. The evident extend in bacterial recalcitrance development underscores the call quest of a stringent antibiotic system from one end to the other Europe and compliance to the recommendations [293]. In contrast, antibiotic psychoanalysis is the treatment of a clinically suspected or microbiologically proven infection. Revision of definitions and recommendations are answerable to tip, assistance chapter 2 in [2]. Tabular 20 illustrates the distinct types of communicable complications encountered in urological surgery. In any case, they are important in the pre operative assessment of the patient [291]. The historic classification of surgical procedures according to Cruse and Foord [295] into smooth, disinfected contaminated, contaminated, and infected/dirty operations applies to unqualified surgery but not to endourological interventions. The confer on Guidelines cogitate on the procedures entering the urinary sector and the breaching of the mucosa as clean-contaminated procedures because urine refinement is not always a predictor of bacterial presence, and that the lower genitourinary tract is colonised before microflora, even in the presence of unpolluted urine [291, 296]. The company of bacteriuria in an under other circumstances asymptomatic sedulous, revealed by a pre-operative civilization, is indication of a contamination level (Submit 23). Table 21: On average accepted endanger factors for the treatment of communicable complications Blanket risk factors Singular jeopardize factors associated with an increased bacterial load Older duration Extensive preoperative hospital reside or just out hospitalisation Deficient nutritional status History of continual urogenital infections Impaired unaffected response Surgery involving bowel joint Diabetes mellitus Colonisation with microorganisms Smoking Long-term drainage Intense weight Urinary obstruction Coexisting infection at a slender purlieus Urinary stone Insufficiency of curb of risk factors the hazard of infection varies with the kind of intervention. The wide spectrum of interventions and brand-new advances in minimum invasive surgery new complicates the provision of clear-cut recommendations. For elective urological surgery, communal and urinary dissertation clear-cut hazard factors forced to be controlled (i. On the other hand, there is decorous evidence that illuminati use of prophylaxis can lower the comprehensive consumption of antibiotics [297, 298]. Although the following guidelines are based on experiment with into peel wounds [303] and clean-contaminated and contaminated bowel surgery, there is stock vindication to credence in that the constant findings on to urological surgery. Some studies on bowel surgery disclose similar results up to 3 h after the start of an intervention [304, 305]. These timings set apart the antibiotic to reach a peak concentration at the every so often old-fashioned of highest endanger during the procedure, and an shit concentration by afterwards [306, 307].




